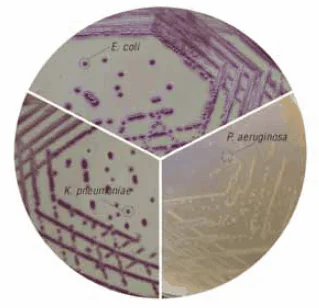
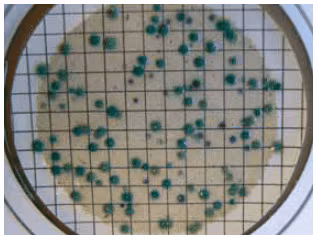

图 1.HiCrome™快速大肠菌群肉汤
显色培养基的优势:
- 更快的结果(与传统方法相比)
- 可靠的视觉检测(通常无需进一步测试)
- 可以直接从培养基进行其他测试
近年来,显色培养基的研究取得了很大进展。最初的研究集中于使用合成底物检测酶促微生物活性。此时使用硝基苯酚和硝基苯胺化合物,产生黄色。然而,硝基苯酚的颜色受pH变化的影响,使得难以在微生物学中可靠地使用。后来的发展包括使用萘酚或萘胺。如今,尽管有各种各样的现代显色底物可供使用,但大多数现代底物都基于吲哚基底物。这样,使用不同的发色团和代谢产物衍生物就可以在一种测定中检测出各种酶活性。吲哚基底物的颜色可以如下:蓝色(5-溴-4-氯-3-吲哚基-= X,3-吲哚基-= Y),洋红色(5-溴-6-氯-3-吲哚基-),鲑鱼(6-氯-3-吲哚基-),紫色(5-碘-3-吲哚基-)和绿色(N-甲基吲哚基-)。吲哚基和这些发色团的主要优点之一是它们保留在细胞中,从而可以表征单个细胞(不扩散到培养基中)。
在过去的一年里,关于酶和物种特异性的知识也有了进一步的进展。选择性试剂和各种生色底物开发方面的这些最新进展已导致可用于满足客户独特分析重点的各种显色培养基(表1和2)。
新型CP ChromoSelect琼脂
欧洲饮用水质量指令在参考方法中建议使用mCP琼脂回收产气荚膜梭菌。在本研究中,评估了三种培养基(mCP、TSCF 和 CP ChromoSelect 琼脂)在不同水样中产气荚膜梭菌的回收率。在使用膜过滤技术测试的 139 个水样品中,发现至少 131 种(94.2%)的分析样品在至少一种培养基上对产气荚膜梭菌呈阳性。
CP ChromoSelect琼脂(CCP琼脂)上的绿色菌落被算作产气荚膜梭菌的分离株。在CCP琼脂上的483个绿色菌落中,96.9%(465个菌落,吲哚阴性)被鉴定为产气荚膜梭菌,15个菌落(3.1%)为吲哚阳性,并被鉴定为C. sordelli、C. bifermentans或C. tetani。仅3株(0.6%)给出假阳性结果,并被鉴定为C. fallax、C. botulinum和C. tertium。数据方差分析显示,在本工作中使用的不同培养基之间获得的计数没有统计学上的显著差异。
mCP方法在常规筛选中工作非常繁重,并且细菌菌落不能用于进一步的生化测试。相反,CCP和TSC上的菌落易于计数和继代培养以进行确认测试。TSCF不仅检测产气荚膜梭菌,还检测所有减少亚硫酸盐的梭状芽胞杆菌;但是,在某些情况下,琼脂过度变黑会影响较低稀释度的计数。如果污染太高,TSCF不能始终如一地产生黑色菌落,结果,菌落的白色给出了假阴性结果。
从所有培养基中分离的典型和非典型菌落的鉴定已经证明,CCP琼脂是水样品中的产气荚膜梭菌回收的最特异性培养基。
图 2.HiCrome™ ECC琼脂(73009)

图 3.HiCrome™ 大肠菌琼脂(81938)
图 4.CP ChromoSelect琼脂(Cl.Perfringens显示为绿色菌落,12398)
材料
如要继续阅读,请登录或创建帐户。
暂无帐户?